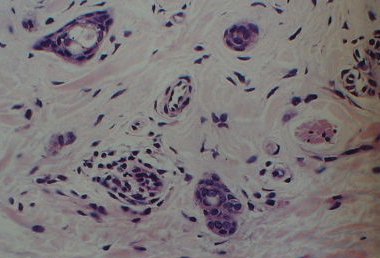

Syringoma
Syringoma showing ducts surrounded by the abnormal epithelial cells. Return to case 1 |
Brow

Pilomatrixoma. Brow area is a common site for this lesion. The differential diagnosis include epidermoid and dermoid cyst. In long-standing cases, calcification may be seen. Return to case 2 |
Magnified

Magnified view of pilomatrixoma. B represents the basophilic cells. S the shadow (ghost) cells. Note the central clear areas. C areas of calcification. Return to case 2 |